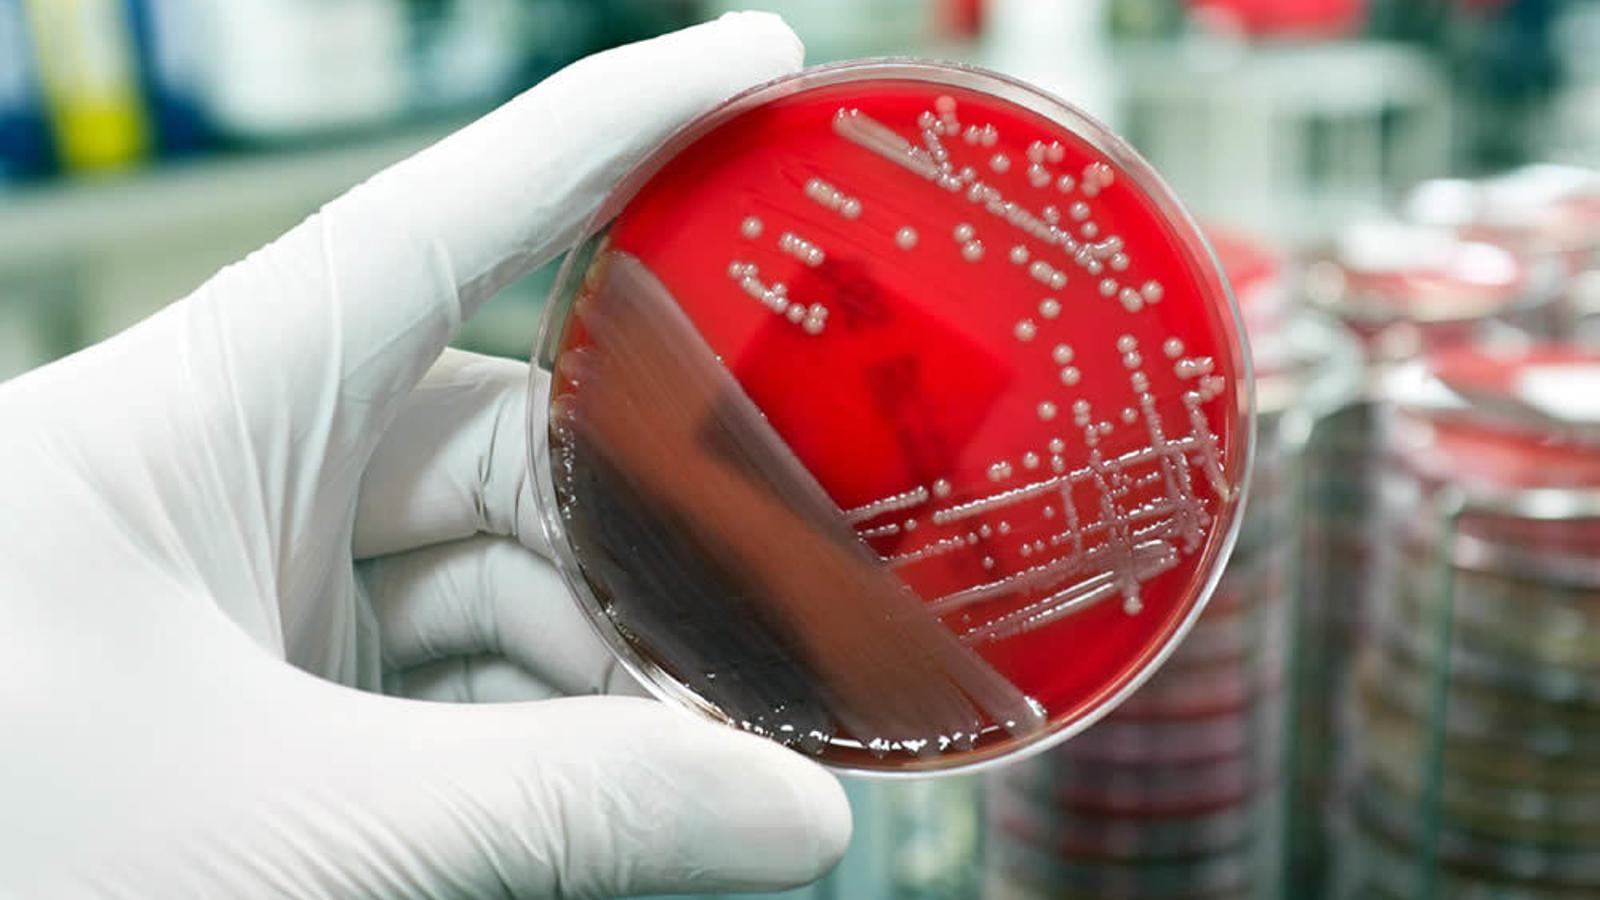
Técnico en un laboratorio - Archivo

La prevención es la mejor manera de entender la salud y es el eje sobre el que se asienta la filosofía One Health, una estrategia que ayuda a abordar el problema de las bacterias multirresistentes en alimentos. Así se ha puesto de relieve en el XXIV Simposio Nacional de Microbiología Alimentaria de bioMérieux en el que los expertos han debatido cómo mejorar los controles de calidad en alimentación y cómo el uso de la microbiología rápida ha contribuido a mejorar la eficiencia de las plantas de producción y la seguridad de los alimentos que consumimos.
"La microbiología ha sido esencial en la mejora de la salud de los consumidores", apunta José Juan Rodríguez, profesor titular del Área de Nutrición y de Bromatología en la UAB y ponente en este simposio. “Hace escasamente 100 años la esperanza de vida era menos de la mitad de la actual; las personas morían por multitud de enfermedades infecciosas, en muchas ocasiones relacionadas con el consumo de alimentos, como el cólera o el tifus. Enfermedades que prácticamente han desaparecido gracias a la incorporación de la microbiología en los procesos de fabricación alimentaria", ha añadido.
En este sentido, la rapidez en la detección de estos microorganismos se ha convertido en un elemento crucial, no sólo para la salud de los consumidores, sino también para la eficiencia de las plantas productoras. "Las técnicas rápidas permiten la adopción de medidas en un menor tiempo que el análisis tradicional. Para poder gestionar la seguridad alimentaria y gestionar el riesgo, las técnicas rápidas son esenciales. No se pueden garantizar alimentos seguros sin estas herramientas microbiológicas", ha explicado este experto.
DETECCIÓN PRECOZ
La detección precoz de los microorganismos presentes en los alimentos de consumo humano cobra todavía más relevancia en un contexto en el que la existencia de bacterias multirresistentes se ha convertido en un problema de salud pública a escala mundial. Sobre este tema, los ponentes han incidido en la necesidad de hacer un uso responsable de los antibióticos en ganadería y han explicado las consecuencias que su uso abusivo puede tener para la salud humana y animal.
Por este motivo, los expertos han apostado por abordar la problemática a través de una estrategia One Health, que implica comprender que salud humana, veterinaria, alimentación y medioambiente son ámbitos interconectados y que las bacterias viajan por estos medios indistintamente.
Actualmente, según han señalado, faltan alternativas terapéuticas con nuevas moléculas y mecanismos de acción para algunos tipos de bacterias multirresistentes. En este sentido, los expertos han apuntado que realizar un diagnóstico de precisión sobre las causas de las patologías en veterinaria y salud humana es una estrategia a tener en cuenta en la lucha contra las enfermedades infecciosas.
A lo largo del simposio se han debatido también los principales cambios de la norma ISO 17025 que aplica a los laboratorios de ensayo y calibración, así como los servicios Lean 6 Sigma para maximizar el rendimiento del laboratorio. Todo ello, con el objetivo de contribuir a que los laboratorios sean lugares eficientes.